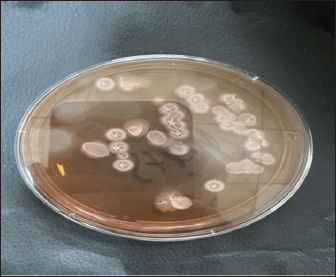

| Research Article | ||
Open Vet. J.. 2026; 16(1): 469-477 Open Veterinary Journal, (2026), Vol. 16(1): 469-477 Research Article Dose-dependent effects of an indigenous Bacillus subtilis on hepatic and renal histoarchitecture in common carp (Cyprinus carpio)Havan Dawd Sleman* and Nasreen Mohialddin AbdulrahmanCollege of Veterinary Medicine, University of Sulaimani, Sulaimaniya, Iraq *Corresponding Author: Havan Dawdd Sleman. College of Veterinary Medicine, University of Sulaimani, Sulaimaniya, Iraq. Email: havan.sleman [at] univsul.edu.iq Submitted: 20/05/2025 Revised: 11/11/2025 Accepted: 04/12/2025 Published: 31/01/2026 © 2025 Open Veterinary Journal
AbstractBackground: The increasing need for sustainable aquaculture practices has directed attention toward probiotics as viable, eco-friendly alternatives to antibiotics. Bacillus subtilis, a resilient, spore-forming bacterium, is recognized for its immunomodulatory and growth-promoting potential in aquaculture species. Aim: This study aimed to assess the histopathological effects of dietary inclusion of an indigenous B. subtilis, isolated from the intestinal tract of common carp (Cyprinus carpio), administered at graded levels to determine dose-dependent tissue responses. Methods: A controlled 8-week feeding trial was conducted on 72 common carp randomly assigned to four dietary treatments: a basal control diet and three diets supplemented with B. subtilis at 1, 10, and 100 mg/kg feed. The bacterial strain was taxonomically validated through molecular identification of the isolate by 16S rRNA and endoglucanase gene amplification. Post-trial, hepatic and renal tissues were processed for histopathological analysis using hematoxylin and eosin staining to assess structural integrity and pathological changes. Results: Histological examination revealed a clear dose-dependent pattern of tissue response. The 1 mg/kg group exhibited minor histological alterations, including mild glomerular swelling and slight renal hemorrhage, with largely preserved tissue architecture. At 10 mg/kg, moderate renal tubule degeneration, epithelial desquamation, and the formation of hyaline casts were observed, suggesting early nephrotoxic effects. The highest supplementation level (100 mg/kg) induced pronounced hepatic degeneration characterized by cytoplasmic vacuolation, sinusoidal dilatation, Kupffer cell hyperplasia, vascular congestion, and mild periportal inflammation. Similarly, renal tissues exhibited tubular necrosis, glomerular atrophy, and interstitial hemorrhage. No pathological changes were observed in control fish, which displayed intact hepatic and renal architecture. Conclusion: Low-dose dietary supplementation (1 mg/kg) of indigenous B. subtilis appears histologically safe, showing only mild alterations without functional impairment. However, higher doses may induce moderate tissue damage. Dose optimization is essential for the safe and effective use of native probiotics in aquaculture. Keywords: Bacillus subtilis, Histological biomarkers, Dose-dependent effects, Fish tissue integrity, Aquaculture probiotics. IntroductionAquaculture has become an essential contributor to global food security, playing a pivotal role in meeting the rising demand for animal protein. In 2018, the global production of aquatic animals produced 179 million tons, of which aquaculture alone contributed 82.1 million tons (FAO, 2024). Among freshwater species, the common carp (Cyprinus carpio) is one of the most widely cultured fish, accounting for 4.19 million tons of global production. Its adaptability, fast growth rate, and compatibility with pond-based farming systems highlight its economic importance in aquaculture (FAO, 2024). With the ongoing expansion of aquaculture, the industry’s focus has shifted toward enhancing fish growth, maintaining physiological health, and ensuring high product quality. These improvements are largely driven by advancements in feed formulations tailored to the nutritional requirements of cultured species (Gule and Geremew, 2022). However, the routine use of antibiotics to control disease has raised serious environmental and public health concerns, including the emergence of antibiotic-resistant bacteria. This challenge has accelerated the search for sustainable, non-antibiotic alternatives to support fish health and productivity, particularly probiotics (Arumugam et al., 2023). Probiotics are defined as live microorganisms that confer health benefits to the host when administered in adequate amounts (Amenyogbe, 2023). In aquaculture, their use has been associated with enhanced growth performance, improved feed utilization, strengthened immune responses, and reduced disease incidence (Nayak, 2021). Additionally, probiotics can improve water quality and serve as biological agents for bioremediation in aquatic systems (Nayak, 2021). These beneficial microbes—encompassing bacteria, yeasts, and microalgae—modulate gut microbiota, facilitate nutrient absorption, and stimulate host immune functions (Oleskin and Boyang, 2022). Among probiotic candidates, Bacillus species—especially Bacillus subtilis—have attracted considerable interest. These Gram-positive, catalase-positive, spore-forming bacteria are highly resilient, capable of surviving extreme environmental conditions due to their endospore-forming ability (James et al., 2021; Nayak, 2021). In aquaculture, B. subtilis supplementation has been widely reported to improve growth performance, enhance feed digestibility, modulate gut microbial communities, and activate both local and systemic immune responses (Tachibana et al., 2021). Its mechanisms of action include enzyme production, competitive exclusion of pathogens, and immunostimulation. Emerging evidence further supports the multifaceted roles of B. subtilis in promoting fish health. Dietary supplementation has been shown to enhance intestinal structure, increase nutrient absorption, and improve immune-related gene expression (Su et al., 2025). Notably, B. subtilis also contributes to lipid metabolism and liver function, underlining its systemic impact on fish physiology. In combination with other probiotic strains, such as Bacillus licheniformis, it has been observed to enhance microbial diversity in the gut and inhibit the growth of opportunistic pathogens (Tachibana et al., 2021; Silvester et al., 2022). Despite these promising outcomes, the tissue-level effects of native probiotic strains—particularly those isolated from the host species—remain insufficiently understood. Indigenous strains may exhibit superior colonization and compatibility compared to foreign commercial strains. Therefore, the present study aims to assess the histopathological effects of B. subtilis, isolated from the intestinal tract of C. carpio, on hepatic and renal tissues. By incorporating this locally derived probiotic into fish diets, this research seeks to evaluate its potential to safeguard organ integrity, reduce histological damage, and support systemic health under intensive culture conditions. The findings contribute to the development of sustainable, host-specific probiotic strategies that align with antibiotic-free aquaculture goals. Materials and MethodsProbiotic strain isolation and identificationBacterial isolation This study was conducted at the Fish Diseases Laboratory, College of Veterinary Medicine, University of Sulaimani. Five healthy Common carp (C. carpio), averaging 1,500 ± 100 g, were collected from a local market in Sulaimani in August 2024 for the isolation of B. subtilis. Upon arrival, the fish underwent salt immersion treatment to remove external pathogens, followed by anesthesia using clove solution and humane sacrifice. The abdominal surface was disinfected with 70% ethanol, and fish were dissected aseptically. Intestines were removed under sterile conditions, emptied, washed with sterile normal saline, and incubated in peptone water at 37°C for 24 hours. Enriched samples were transferred to nutrient broth and further incubated for 24 hours, then spread on Nutrient Agar (NA) and Mannitol Egg Yolk Polymyxin (MYP) agar for selective isolation (Fig. 1). Colonies with morphological characteristics of Bacillus subtilis were purified and identified using 16S rRNA amplification.
Fig. 1. Selective cultivation of indigenous Bacillus subtilis isolates on MYP agar from the intestinal microbiota of (Cyprinus carpio). Molecular identificationGenomic DNA was extracted from confirmed isolates using a commercial Genomic DNA Kit (Genaid, Korea), following the manufacturer’s protocol. DNA was eluted in 50–100 μl of elution buffer and stored at −20°C. PCR amplification was performed using two specific primer sets targeting the endoglucanase gene (Ashe et al., 2014; Harba et al., 2021) (Table 1). Primers were synthesized by Macrogen (Korea), prepared at 10 pmol/μl, and stored at −20°C until use. Table 1. PCR amplification of the endoglucanase gene using specific primers for molecular identification of Bacillus subtilis isolates.
Dietary formulationFollowing molecular confirmation, the extractive B. subtilis was processed into powdered form at the Fisheries Research Center in Baghdad. A commercial pellet diet (Golden Fish Factory) was first milled into a fine powder, then the prepared B. subtilis strain was added to the milled feed at three different doses—1 mg/kg (BS1), 10 mg/kg (BS2), and 100 mg/kg (BS3)—and thoroughly mixed. A fourth group received the same milled diet without any supplementation (Control – CT). These specific doses were selected to evaluate a broad spectrum of probiotic responses. The 1 mg/kg dose represents a minimal inclusion level, commonly used in preliminary studies to assess baseline physiological tolerance. The 10 mg/kg dose corresponds to a mid-range concentration frequently reported in literature to improve fish health and performance. The highest dose, 100 mg/kg, was chosen to explore potential tissue-level stress responses and to assess safety margins for over-supplementation. The dose range was informed by prior findings on B. subtilis application in aquaculture (Nayak, 2021; Tachibana et al., 2021), ensuring the study addressed both efficacy and safety. The feed mixtures were homogenized, moistened with filtered water, pelletized via cold-press extrusion, and dried at 16°C in a ventilated chamber under sterile conditions, then refrigerated until use. Experimental designIn December 2024, a total of 72 clinically healthy common carp (80–90 g) were obtained from a local farm in Hilla, Iraq, and acclimated for two weeks in 12 tanks [60 l each, (18 fish per group), with three replicates per treatment, six fish per tank] at 21°C. Fish were fed at 3% body weight daily during acclimation with mixed feed, and water parameters (temperature: 23°C ± 1°C, pH: 7.05 ± 0.55, DO: 6.60 ± 0.44 mg/l) were monitored. Over half of the water was changed daily. After acclimation, fish were randomly assigned into four groups (three replicates per group). The feeding trial lasted 8 weeks, during which fish were fed twice daily at 3% body weight, with biweekly adjustments. Histological examinationFor histological analysis, three fish per group were euthanized with clove, and their liver and kidney were fixed in 10% formalin for 24 hour. Samples were dehydrated through an ethanol series, cleared in xylene, and embedded in paraffin. Tissue sections (5 µm) were mounted, air-dried, and stained with hematoxylin and eosin (H&E) (Oleskin and Boyang, 2022). Histopathological evaluation was conducted on the kidney and liver tissues. Kidney alterations were graded from 0 (normal) to 4 (severe) based on the extent of congestion, hemorrhage, and cellular degeneration. Liver sections were similarly graded based on architecture, inflammation, and degenerative changes, including hydropic degeneration and Kupffer cell hyperplasia (Tables 2 and 3). Table 2. Evaluation and scoring criteria of histopathological lesions in kidney tissues, showing severity grades (0–4) with corresponding interpretations.
Table 3. Evaluation and scoring criteria of histopathological lesions in liver tissues, showing severity grades (0–4) with corresponding interpretations.
Ethical approvalAll experimental procedures involving fish were reviewed and approved by the Institutional Ethics and Research Registration Committee of College of Veterinary Medicine/University of Sulaymaniyah, under Approval No. VMUS.EC.Doc 9-2024, granted in December 2024. ResultsMolecular confirmation of B. subtilisPCR amplification of the endoglucanase gene produced 545 bp and 1,311 fragments using Add Start Taq Master Mix under standard conditions, with annealing at 58°C and 60°C, respectively. Products were run on a 1% agarose gel stained with safe dye and visualized with a 100 bp DNA ladder. Clear bands confirmed the gene’s presence, identifying the isolate as B. subtilis (Fig. 2a and b).
Fig. 2. a. Agarose gel electrophoresis image showing PCR product results for B. subtilis targeting the 16S rRNA gene (545 bp). Lane M: 100 bp marker, Lane 1: Negative control, Lanes 2-4: Positive samples (545 bp). b. Agarose gel electrophoresis image showing PCR product results for B. subtilis targeting the endoglucanase gene (1311 bp). Lane M: 100 bp marker, Lane 1: Negative control, Lanes 2-4: Positive samples (1311 bp). Histopathological evaluation of kidneyThe kidney sections in the negative control group exhibited intact and normal features of glomeruli, which included a glomerular tuft, capillary, Bowman’s capsule, juxtaglomerular apparatus, and both proximal and distal convoluted tubules. There was also a large number of hematopoietic cells scattered within the interstitial tissue. In contrast, the group treated with B. Subtilis Probiotic at 1 mg/kg bw showed mild swelling of both the glomeruli and renal tubules, along with mild interstitial hemorrhage. While the B. Subtilis 10 mg/kg bw group displayed more severe lesions, with moderate swelling of renal tubules, mild swelling of glomeruli, mild interstitial hemorrhage, and the presence of hyaline casts—eosinophilic amorphous material observed in the renal tubules. In the group receiving B. subtilis at 100 mg/kg bw, the damage was more pronounced, showing moderate hemorrhage along with a mild inflammatory reaction (Fig. 3a–h). The severity of kidney tissue damage in common carp increased with higher doses of B. subtilis. No damage was seen in the control group G1. Mild signs of glomeruli and tubular degeneration appeared in G2 and worsened in G3 and G4. In G4, additional issues like inflammation and hyaline casts were also present. This suggests that while low doses may be safe, higher doses could stress or harm the kidneys, because they reflect a minimal and reversible adaptive response without signs of severe pathology such as necrosis, hyaline casts, or inflammation. These changes are common in probiotic feeding trials and do not indicate functional impairment or health risk at this dose (Fig. 4).
Fig. 3. Microscopic sections of the kidney in common carp revealed varying histological changes across treatment groups. In the negative control group (a and b), the kidney displayed normal architecture with well-defined glomeruli (G), proximal and distal convoluted tubules (P and D), and abundant hematopoietic cells (Ha). In the group treated with Bacillus subtilis Probiotic at 1 mg/kg bw (c and d), mild swelling of the glomeruli and slight distention of Bowman’s space (G) were observed, along with mild tubular swelling (P and D) and the presence of free red blood cells (black arrows) intermingled with hematopoietic cells. The 10 mg/kg bw group (e and f) exhibited mild glomerular swelling (G), moderate tubular swelling (P and D), hyaline cast formation (H), and a mild presence of free red blood cells (inset) among hematopoietic cells (Ha). In the 100 mg/kg bw group (g and h), the kidney sections showed mild glomerular swelling (G), moderate tubular swelling (P and D), hyaline casts (H), moderate interstitial hemorrhage, abundant hematopoietic cells (Ha), and limited infiltration of inflammatory cells (inset), as observed under (H&E stain).
Fig. 4. Renal histopathological lesions and grading in common carp following dietary treatments. Histopathological evaluation of liverAs for the liver sections, the control negative group presented normal liver architecture with a central vein, rows of hepatocytes separated by tortuous sinusoidal capillaries, and no signs of congestion or inflammation. However, liver tissues from fish treated with B. subtilis displayed progressive histopathological changes correlating with dosage. At 10 and 100 mg/kg bw, there was evidence of moderate hepatic degeneration, characterized by swollen and vacuolated hepatocytes, along with signs of vascular congestion. The highest dose (100 mg/kg bw) also resulted in mild Kupffer cell proliferation, interstitial hemorrhage, and a mild inflammatory response (Fig. 5a–h).
Fig. 5. Microscopic section of liver of Carp Fish in negative control (a and b) revealed; Normal architecture of liver parenchyma with intact hepatocyte (H) and sinusoidal capillary (red arrows), the normal pancreas (P). In Bacillus subtilis Probiotic 1 mg/kg/bw showed; (c and d): Mild hydropic degeneration of hepatocytes, moderate vascular congestion also in the pancreas (black arrows, P), mild Kupffer cell proliferation (red arrows). In Bacillus subtilis 10 mg/kg/bw presented; (e and f): Moderate hydropic degeneration of hepatocytes, moderate vascular congestion even in the pancreas (P and black arrow), Kupffer cell proliferation mildly (red arrows) and slight inflammatory reaction (yellow arrows), in Bacillus subtilis 100 mg/kg/bw showed; (g and h): Moderate hydropic degeneration of hepatocytes, severe vascular congestion with eosinophilic fluid (CV), and pancreatic congestion (P), with free RBC (black arrow), mild Kupffer cell proliferation (red arrows) and mild inflammatory reaction (yellow arrows), (H&E stain). Figure 6 provides a comparative visual grading of hepatic lesion severity across treatment groups. Although statistical significance (e.g., p-values) was not calculated, a consistent trend of increasing hepatic alteration with dose escalation was evident.
Fig. 6. Histopathological grading of liver lesions in Common carp across treatment groups. DiscussionThis study demonstrated that dietary supplementation with an indigenous B. subtilis strain produced dose-dependent histopathological effects in the liver and kidney of common carp (C. carpio). Of Bacillus subtilis at a low dose of 1 mg/kg resulted in mild renal histological alterations compared to control fish, which showed normal tissue architecture. Previous studies have reported that subtle tissue remodeling following probiotic administration may be associated with enhanced stress tolerance in fish (Eissa et al., 2025). Therefore, while low-dose B. subtilis causes minor structural changes, it does not negatively affect overall fish performance and can be considered safe under the conditions tested. However, moderate to severe tissue alterations at higher inclusion levels (10 and 100 mg/kg), including renal tubular degeneration, hepatic vacuolation, and vascular congestion, suggest potential physiological stress or toxicity associated with probiotic overuse. These findings contrast with Eissa et al. (2025), who reported that increasing dietary doses of B. subtilis led to considerable structural modulation in fish organs but concluded that overall health was enhanced. Conversely, the current study aligns with concerns raised by Nayak (2010), who emphasized that excessive probiotic administration can disrupt host-microbe equilibrium and trigger inflammatory or degenerative tissue responses. The hepatic and renal alterations at higher doses observed here suggest that even beneficial microbes, if over-supplemented, may act as metabolic stressors or elicit unintended immune responses (Hai, 2015). Although the present study was limited to an 8-week feeding period, it is important to consider that long-term use of probiotics may produce different physiological responses. Prolonged exposure to low or moderate doses could reinforce mucosal immunity, stabilize gut microbiota, and enhance organ resilience. However, continuous administration of high concentrations may increase the risk of microbial imbalance or subclinical stress responses over time. Further chronic exposure studies are therefore recommended to validate the sustained safety and efficacy of indigenous probiotic strains in aquaculture (Philips et al., 2024). The tissue-level changes observed in this study may be attributed to underlying molecular or physiological disruptions induced by excess probiotic exposure. At elevated doses, B. subtilis may alter the balance of gut microbiota, leading to overproduction of reactive oxygen species and oxidative stress in hepatic and renal tissues (Sun et al., 2024). This oxidative burden can compromise mitochondrial integrity, impair membrane function, and disrupt cellular homeostasis, thereby triggering hepatocellular vacuolation and renal tubular degeneration. Additionally, overstimulation of the host immune system may result in inflammatory cascades, characterized by Kupffer cell proliferation in the liver and leukocyte infiltration in the kidneys. These responses, while part of the body’s defense mechanism, can become pathological if sustained or exacerbated by high probiotic loads (Singh et al., 2022; Semenova et al., 2024). Therefore, it is critical to define safe and effective dose thresholds when introducing probiotics into aquafeeds. While indigenous strains may offer ecological compatibility and host-specific benefits (Balcázar et al., 2006), this study reinforces the importance of dose optimization. Long-term exposure to high probiotic concentrations should be approached cautiously and validated with comprehensive histological and physiological evaluations. Nevertheless, this study has some limitations. First, the histological assessment was performed after a short-term feeding trial, and only a limited number of tissue samples (n=3 per treatment) were examined. This small sample size may not fully capture the variability of tissue responses, and conclusions about long-term safety remain preliminary. Additionally, statistical analysis was not applied to the histological findings because the evaluation was based on qualitative histopathological scoring, which is descriptive in nature and not suitable for conventional statistical testing. Further studies are recommended to evaluate the chronic impacts of probiotic administration using larger sample sizes, extended durations, and quantitative methods that allow for statistical comparison. ConclusionThis study investigated the isolation, molecular identification, dietary formulation, and experimental evaluation of an indigenous B. subtilis strain in common carp (Cyprinus carpio). The probiotic was administered in three different doses (1, 10, and 100 mg/kg) to assess its effects on fish health, particularly focusing on liver and kidney histopathology. The results demonstrated a dose-dependent response. At 1 mg/kg, B. subtilis appeared histologically safe, with only mild, reversible changes observed in kidney tissues and no significant alterations in liver architecture. However, higher doses (10 and 100 mg/kg) led to moderate renal and hepatic degeneration, including glomerular swelling, interstitial hemorrhage, hepatocyte vacuolation, vascular congestion, and Kupffer cell proliferation. Molecular confirmation through PCR validated the identity of the probiotic strain, and the histological findings indicated that while low-dose supplementation may be beneficial or at least non-damaging, excessive levels could induce stress-related tissue alterations. These findings emphasize the importance of probiotic dose optimization to balance efficacy and safety in aquaculture. Overall, this research highlights the potential of native B. subtilis as a sustainable probiotic in aquaculture, provided that its inclusion level is carefully managed. Future studies with larger sample sizes and extended durations are recommended to validate these findings, with a particular focus on long-term functional outcomes, immunological responses, and growth performance at optimized doses to confirm the practical benefits of indigenous probiotics in fish farming. AcknowledgmentsNone. Conflict of interestNo potential conflict of interest was reported by the authors. FundingNone. Authors’ contributionsHavan Dwud Sleman: Conducted the experiments, analyzed the data, and wrote the manuscript, isolated and characterized the Bacillus subtilis strain, and performed microbiological analyses, carried out the feeding trial, and growth performance analysis. Nasreen Mohialddin Abdulrahman: Conceived and designed the study, provided critical review and revisions of the manuscript, assisted in data analysis, interpretation, and reviewed the manuscript. All authors read and approved the final manuscript. Data availabilityAll data were provided in the manuscript. ReferencesAmenyogbe, E. 2023. Application of probiotics for sustainable and environment-friendly aquaculture management-A review. Cogent. Food. &. Agriculture. 9(1), 2226425. Arumugam, M., Jayaraman, S., Sridhar, A., Venkatasamy, V., Brown, P.B., Abdul Kari, Z., Tellez-Isaias, G. and Ramasamy, T. 2023. Recent advances in tilapia production for sustainable developments in Indian aquaculture and its economic benefits. Fishes 8(4), 170. Ashe, S., Maji, U.J., Sen, R., Mohanty, S. and Maiti, N.K. 2014. Specific oligonucleotide primers for detection of endoglucanase positive Bacillus subtilis by PCR. 3. Biotech. 4(5), 461–465. Balcázar, J.L., De Blas, I., Ruiz-Zarzuela, I., Cunningham, D., Vendrell, D. and Múzquiz, J.L. 2006. The role of probiotics in aquaculture. Vet. Microbiol. 114(3-4), 173–186. Eissa, E.S.H., Monier, M.N., Abd El-aziz, Y.M., Saadony, S., Abu Husein, M.S., Abd El Megeed, O.H. and Sakr, S.E.S. 2025. The efficacy of dietary commercial probiotic (Bacillus subtilis) on growth performance, hemato-biochemical response, and histological status of red tilapia (Oreochromis sp.). J. Appl. Aquac. 37(1), 45–66. Food and Agriculture Organization of the United Nations (FAO). 2024. The State of World Fisheries and Aquaculture: Blue Transformation in Action. Rome, Italy: FAO-Food and Agriculture Organization of the United Nations. Gule, T.T. and Geremew, A. 2022. Dietary strategies for better utilization of aquafeeds in tilapia farming. Aquac. Nutr. 2022, 9810074. Hai, N.V. 2015. The use of probiotics in aquaculture. J. Appl. Microbiol. 119(4), 917–935. Harba, M., Jawhar, M. and Arabi, M.I.E. 2021. Heterogeneity within the 16S rRNA gene of Bacillus subtilis isolates differing with antagonistic activity against Cochliobolus sativus pathogen. J. Agroaliment. Processes Technol. 27(2). James, G., Das, B.C., Jose, S. and V.J, R.K. 2021. Bacillus as an aquaculture-friendly microbe. Aquac. Int. 29(1), 323–353. Nayak, S.K. 2010. Role of gastrointestinal microbiota in fish. Aquac. Res. 41(11), 1553–1573. Nayak, S.K. 2021. Multifaceted applications of probiotic Bacillus species in aquaculture with special reference to Bacillus subtilis. Rev. Aquac. 13(2), 862–906. Oleskin, A.V. and Boyang, C. 2022. Microalgae in terms of biomedical technology: probiotics, prebiotics, and metabiotics. Appl. Biochem. Microbiol. 58(6), 813–825. Philips, C.A., Ahamed, R., Oommen, T.T., Nahaz, N., Tharakan, A., Rajesh, S. and Augustine, P. 2024. Clinical outcomes and associated bacterial and fungal microbiota changes after high dose probiotic therapy for severe alcohol-associated hepatitis: an observational study. Medicine 103(45), e40429. Semenova, N., Garashchenko, N., Kolesnikov, S., Darenskaya, M. and Kolesnikova, L. 2024. Gut Microbiome Interactions with Oxidative Stress: mechanisms and Consequences for Health. Pathophysiology 31(3), 309–330. Silvester, R., Madhavan, A., Kokkat, A., Parolla, A., B.M., A., M., H. and Abdulla, M.H. 2022. Global surveillance of antimicrobial resistance and hypervirulence in Klebsiella pneumoniae from LMICs: an in-silico approach. Sci. Total Environ. 802, 149838. Singh, V., Ahlawat, S., Mohan, H., Gill, S.S. and Sharma, K.K. 2022. Balancing reactive oxygen species generation by rebooting gut microbiota. J. Appl. Microbiol. 132(6), 4112–4129. Su, Q., Peng, X., Zhang, Z., Xiong, Z., He, B., Chu, P. and Zhu, C. 2025. Isolation, characterization of Bacillus subtilis and Bacillus amyloliquefaciens and validation of the potential probiotic efficacy on growth, immunity, and gut microbiota in hybrid sturgeon (Acipenser baerii♀ × Acipenser schrenckii♂). Fish Shellfish Immunol. 157, 110081. Sun, Y., Wang, X., Li, L., Zhong, C., Zhang, Y., Yang, X., Li, M. and Yang, C. 2024. The role of gut microbiota in intestinal disease: from an oxidative stress perspective. Front. Microbiol. 15, 1328324. Tachibana, L., Telli, G.S., Dias, D.D.C., Gonçalves, G.S., Guimarães, M.C., Ishikawa, C.M., Cavalcante, R.B., Natori, M.M., Fernandez Alarcon, M.F., Tapia-Paniagua, S., Moriñigo, M.A., Moyano, F.J., Araújo, E.R.L. and Ranzani-Paiva, M.J.T. 2021. Bacillus subtilis and Bacillus licheniformis in diets for Nile tilapia (Oreochromis niloticus): effects on growth performance, gut microbiota modulation and innate immunology. Aquac. Res. 52(4), 1630–1642. | ||
| How to Cite this Article |
| Pubmed Style Sleman HD, Abdulrahman NM. Dose-dependent effects of an indigenous Bacillus subtilis on hepatic and renal histoarchitecture in common carp (Cyprinus carpio). Open Vet. J.. 2026; 16(1): 469-477. doi:10.5455/OVJ.2026.v16.i1.44 Web Style Sleman HD, Abdulrahman NM. Dose-dependent effects of an indigenous Bacillus subtilis on hepatic and renal histoarchitecture in common carp (Cyprinus carpio). https://www.openveterinaryjournal.com/?mno=259519 [Access: June 22, 2026]. doi:10.5455/OVJ.2026.v16.i1.44 AMA (American Medical Association) Style Sleman HD, Abdulrahman NM. Dose-dependent effects of an indigenous Bacillus subtilis on hepatic and renal histoarchitecture in common carp (Cyprinus carpio). Open Vet. J.. 2026; 16(1): 469-477. doi:10.5455/OVJ.2026.v16.i1.44 Vancouver/ICMJE Style Sleman HD, Abdulrahman NM. Dose-dependent effects of an indigenous Bacillus subtilis on hepatic and renal histoarchitecture in common carp (Cyprinus carpio). Open Vet. J.. (2026), [cited June 22, 2026]; 16(1): 469-477. doi:10.5455/OVJ.2026.v16.i1.44 Harvard Style Sleman, H. D. & Abdulrahman, . N. M. (2026) Dose-dependent effects of an indigenous Bacillus subtilis on hepatic and renal histoarchitecture in common carp (Cyprinus carpio). Open Vet. J., 16 (1), 469-477. doi:10.5455/OVJ.2026.v16.i1.44 Turabian Style Sleman, Havan Dawd, and Nasreen Mohialddin Abdulrahman. 2026. Dose-dependent effects of an indigenous Bacillus subtilis on hepatic and renal histoarchitecture in common carp (Cyprinus carpio). Open Veterinary Journal, 16 (1), 469-477. doi:10.5455/OVJ.2026.v16.i1.44 Chicago Style Sleman, Havan Dawd, and Nasreen Mohialddin Abdulrahman. "Dose-dependent effects of an indigenous Bacillus subtilis on hepatic and renal histoarchitecture in common carp (Cyprinus carpio)." Open Veterinary Journal 16 (2026), 469-477. doi:10.5455/OVJ.2026.v16.i1.44 MLA (The Modern Language Association) Style Sleman, Havan Dawd, and Nasreen Mohialddin Abdulrahman. "Dose-dependent effects of an indigenous Bacillus subtilis on hepatic and renal histoarchitecture in common carp (Cyprinus carpio)." Open Veterinary Journal 16.1 (2026), 469-477. Print. doi:10.5455/OVJ.2026.v16.i1.44 APA (American Psychological Association) Style Sleman, H. D. & Abdulrahman, . N. M. (2026) Dose-dependent effects of an indigenous Bacillus subtilis on hepatic and renal histoarchitecture in common carp (Cyprinus carpio). Open Veterinary Journal, 16 (1), 469-477. doi:10.5455/OVJ.2026.v16.i1.44 |